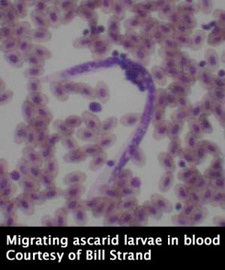

The Worms Treated by Fenbendazole
By Dmitry B. Vassiliev, DVM, PhD
Citation:
Vassiliev, D.B. (2002). The Worms Treated by Fenbendazole. Chameleons! Online E-Zine, July 2002. (http://www.chameleonnews.com/02JulVassilievWorms.html)
Introduction by the CHAMELEONS! staff:
As an addition to the article on Panacur Dr. Vassiliev has given details on the major groups of parasites that Panacur is effective against. In the following paragraphs the active ingredient, Fenbendazole, is stated. This is to recognize that other drugs using Fenbendazole may effective against these parasites.
The Worms Treated by Fenbendazole

These nematodes feed on carbohydrates mostly in the small intestine. They start their life as eggs expelled from their host in feces. Pinworms have a direct lifecycle so the eggs wait to be ingested by another (or the same) host. This will most likely occur through a food item that hashad contact with the feces of the chameleon. Once the host (in this case, a chameleon) ingests them, the eggs stay in the stomach until they hatch. Their small size keeps them from being forced into the small intestine. The hatched larvae are free swimming and make their way to the small intestine where they will grow by ingesting the carbohydrates that are meant for the chameleon. In the small intestine they mature, mate, and die. Gravid females will swim past the sphincter into the large intestine. Here they will lay their eggs. Pinworms are detected by visual inspection of the feces where .5cm (0.2in) females may be seen or by spotting eggs via microscope aided fecal analysis. Fenbendazole is effective against the larvae in the small intestine and somewhat effective against the females in the large intestine. The females in the large intestine may escape the drug if they have embedded themselves in the feces. Pinworms are not directly dangerous unless they are in high concentrations.


Larvae of Spirurids embed themselves in the stomach wall. They produce a reaction in the stomach wall that covers them in a mound of tissue. Different species burrow different depths. Fenbendazole is effective against the species that burrow close to the surface. There may be many of these parasites that make their home under one tumor. The tumor created above them is not thick enough to protect them from Fenbendazole. For species that burrow more deeply a systemic drug such as Ivermectin or Levamisole HCl may be used. From inside their "cave" they get nutrition from the stomach cavity and nutrients from the tissues that surround them. These parasites are very host specific and may not be able to jump even between species of chameleons. They have an indirect lifecycle and depend on a vector, such as a fly, to ingest the eggs and within the vector the eggs hatch and develop to a second stage larvae (one molt). Infestation of the definitive host (the chameleon) occurs after swallowing of the intermediate host (in this case, the fly).
The danger they pose is indirect and comes from producing malnutrition in the chameleon. The tumors that are created above each larvae do not produce digestive juices and, therefore, digestion is compromised. In large amounts, these larvae produce enough tumors that the stomach volume is reduced and the ability to move food through the stomach to the small intestine is impeded.
Spirurids are detected by eggs in feces under a microscope. They are double-walled X with four tubercles and a well developed larvae.
Many times a treatment will serve only to stop egg production. As egg detection is the only way to detect Spirurids this may give a false negative. The Spirurids may then continue egg production at a later time. Regular check ups are needed to control this parasite. If the drug is effective and they die inside the gastric wall the stomach will encapsulate the dead body and, over time, the dead body will be absorbed and the stomach wall area reclaimed.

Hookworms
Hookworms are truly nasty parasites and these blood feeders are deadly. They can be found in any point within the gastrointestinal tract from esophagus to cloaca. They will attach themselves to the walls by burrowing themselves into the gastro wall. They induce direct effects. They suck out great amounts of blood and can cause anemia. They also induce chronic inflammation and give opportunistic microflora inside the gastrointestinal tract the chance to infect the host. A common disease resulting for hookworm activity is chronic productive gastroenteritis (Inflammation of the gut walls) and can effect nutrient absorption and produce diarrhea, blood diarrhea (diarrhea with blood), the accompanying blood poisoning that occurs when feces are introduced to the blood stream and even rotting of the mucus surfaces.
Hookworms have a direct life cycle. Eggs are found in fecal checks and sometimes adults will be seen under a microscope as well. As they stay close to the surface of the gut walls, Fenbendazole is still effective. After treatment the only effect to be seen is the ceasing of egg production as the adults will stay stuck in the mucus walls to be flushed out over the course of time. Eggs contain developed larvae and if the egg hatches in the feces the larvae may spread out in the cage and may even infect other cages if instruments or insects transport them. Hookworms are particularly dangerous because they can penetrate mucus areas of the mouth. Therefore, the chameleon does not need to swallow the eggs to be infested, but only come into contact with the worms by actions such as drinking or being handled by hands that have picked up the microscopic larvae elsewhere.


This is the group that hookworms belong to. Lifecycle is similar to hookworms. The only difference is that other strongylides cannot burrow into skin and are not blood feeding. They produce moving larvae and eat mucus and food/tissue nutrients. They are detected by eggs or well-developed moving larvae under the microscope. In feces two or three days old the eggs will have hatched and only moving larvae will be seen.

Ascarids can be very large (a few centimeters) and are visible to the naked eye. Ascarids live in the stomach and upper part of small intestine. These worms will burrow into the gastric walls. They can burrow just their head into the wall or burrow in and out of the wall coming back out inside the intestines or stomach. Sometimes they can burrow outside the gastrointestinal wall into the body cavity and then will starve.
Some species are blood sucking (and are red colored) and some species feed on nutrients produced by tissues. In the gastro tract they can feed on nutrients from the food. It is my speculation that, when the host goes off feed, these parasites may become more aggressive and attack the host's tissues. They are able to swim against peristaltic action (the gastrointestinal tracts pushing of the food). Although adults can be seen in regurgitated food and, sometimes, in feces, the usual method is to detect eggs in feces under a microscope. Some species have a direct and some an indirect lifecycle. Some may use both methods. Eggs are swallowed by either the chameleon or a vector that is eaten and will hatch inside the chameleon.
Their life cycle starts by hatching inside the stomach or small intestine and burrow through the gastro wall to find the first blood or lymphatic vessel they can find. Their goal is to find the lungs, via the heart, where they will develop into adults. They find the heart by either a lymphatic vessel which will take them directly to the heart or by a blood vessel which will take them to the liver. From the liver they switch to a vein which will take them to the heart. From the heart they can make their way to the lungs by swimming in the blood stream. In the lung they molt and mature as they eat the mucus in the lung. Larvae cannot feed by using their mouth so they absorb nutrients through their skin.
The ascarid has four stages to its life. The first is the newly hatched larvae, the second is the first molt in the blood stream. The third is the first molt in the lung and the fourth stage is after the second molt in the lung. In the fourth stage of the larvae they can infest the gastrointestinal tract. They can produce acute lung inflammation induced by rising exudate (molting and feces) in lungs. The fourth stage ascarid larvae uses the cilial action of the lungs (the method by which the lungs clean themselves) to transport it to the throat of the chameleon. The chameleon then swallows the larvae and the ascarid is able to continue its life cycle in the gastrointestinal tract.
During its travels, an ascarid can produce reactions in the liver and the lungs that can pave the way for opportunistic microflora. Because of their large size they can affect mobility of the gastrointestinal tract. Fenbendazole works well against adults, but not against other stages as it does not get to the blood, liver, or lungs. After treatment, the dead bodies of the adults may be seen in feces. Because Fenbendazole works slowly it may take a number of days for the worms to be ejected. Worms weakened by the drug, but not killed may resist peristaltic action for a time.
Ascarids are detected by finding eggs in fecal matter under a microscope.



Same as an ascarid life cycle, but stay in lungs after third stage and live in lungs permanently. Larvae can penetrate skin like hookworm and can live in cage environment for a long time. Eggs are laid in the lungs and are moved up out of the lungs by cillial action of the upper respiratory tract to be swallowed into the stomach or be released into the environment during drinking or dropping out of the mouth or nose. Larvae can hatch in the lungs and actively move towards its destination. There is only one genus (Entomelas). Some of the species are blood-feeders and can have a red color. After hatching they can develop a free-lived generation with two different sexes which can live in the environment for a long period of time producing not-invasive larvae. For some reason, after a time, they start producing so-called filariaform larvae that can infest chameleons by direct penetration of skin or by swallowing. They then burrow out of the gastro wall and look for the blood vessel and liver and lung. The parasitic generation contains only females which produce eggs using parthenogenic means. When you treat animals with Fenbendazole you can only hope to kill the larvae in the gastrointestinal tract. I have not personally observed a pronounced therapeutic effects after treatment against lungworms in various species of reptiles.
They are detected by fecal analysis. The eggs may last only one day in the feces so a fresh sample may show eggs and free moving larvae, but an older sample will show only larvae. The morphology of the larvae is almost identical to some other nematodes. To truly identify the larvae as lung worms saliva or sputum (phlegm from trachea) from lungs must be analyzed.
Formatting, compilation, and editing for this article provided by Bill Strand

Dmitry B. Vassiliev, DVM, PhD

Dr. Dmitry B. Vassiliev D.V.M., PhD is the senior herpetologist at the Moscow Zoo in Russia. He is an ARAV member and has published many articles in Russian, Japanese, and German journals on topics such as captive breeding of elapid snakes, shiniasaurus, and a variety of pythons. In the last ten years he has worked in veterinarian support of reptiles particularily in the field of parasitology, comparative pathology, and surgery. His travels have led him from Irian Jaya to Mongolia to Europe.
Join Our Facebook Page for Updates on New Issues:
© 2002-2014 Chameleonnews.com All rights reserved.
Reproduction in whole or part expressly forbidden without permission from the publisher. For permission, please contact the editor at editor@chameleonnews.com